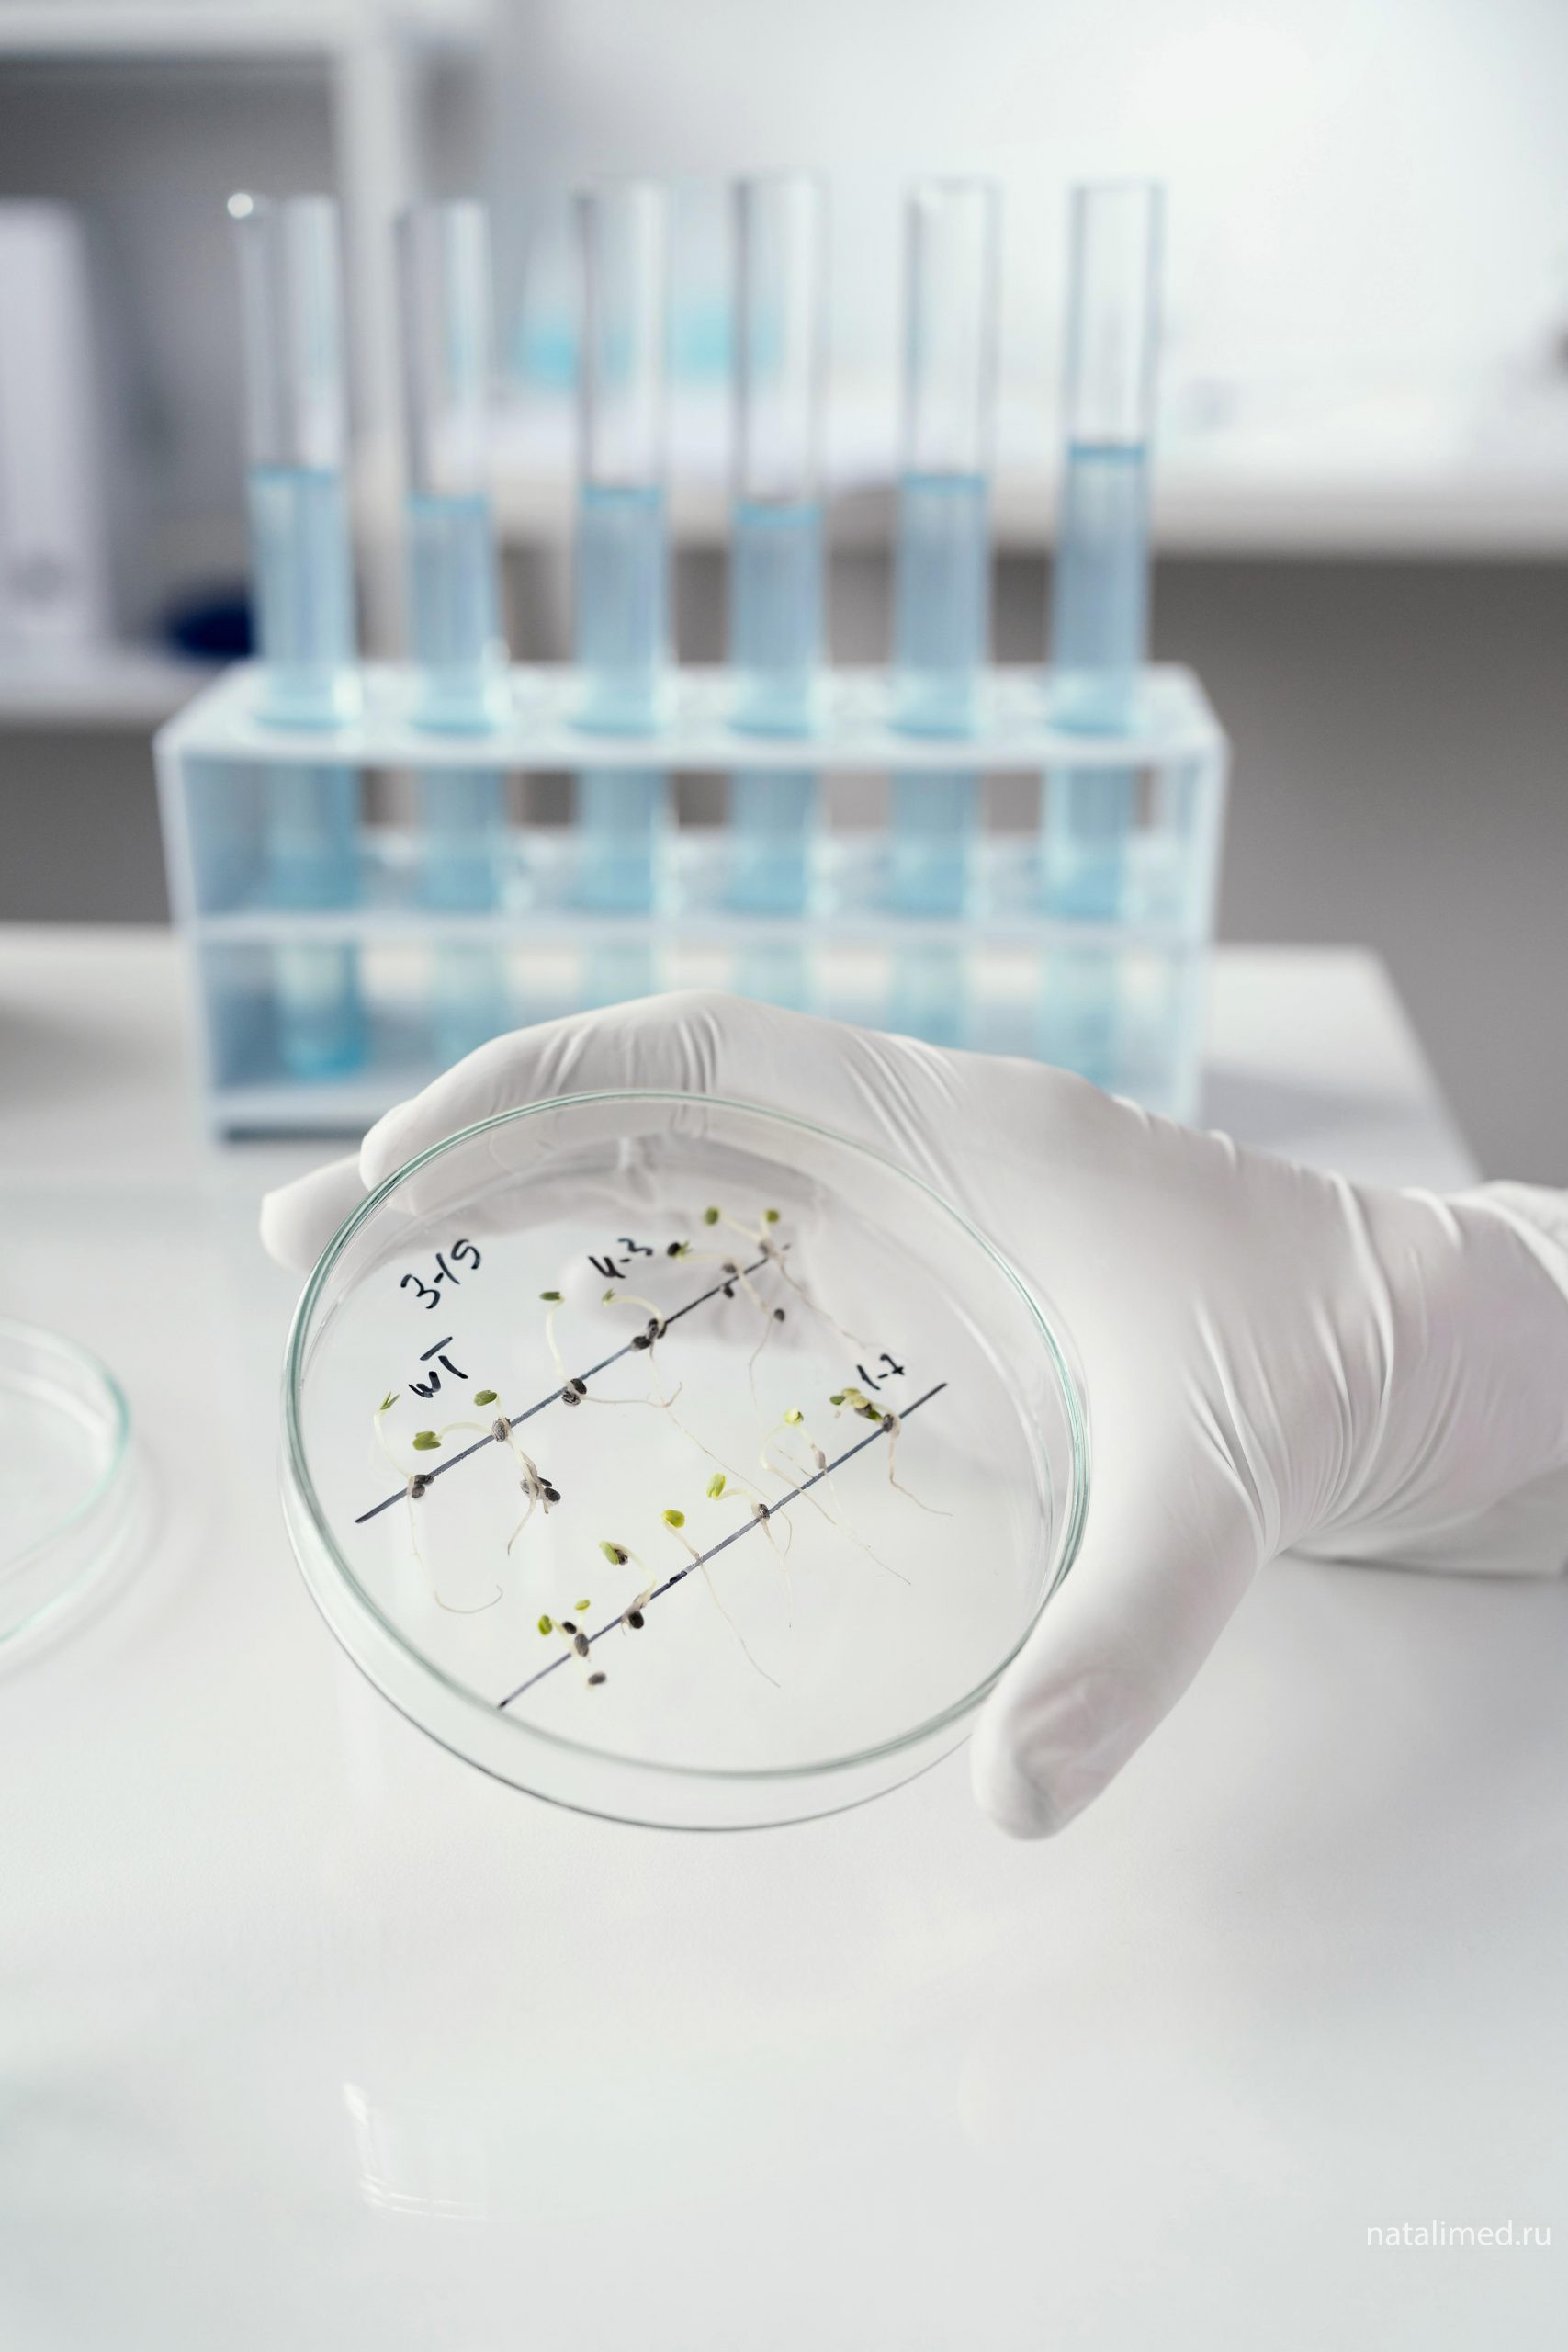

Лаборатоорная диагностика — совокупность методов, направленных на анализ исследуемого материала с помощью различного специализированного оборудования.
Основной задачей является выявление или подтверждение наличия патологии, которую невозможно однозначно подтвердить или опровергнуть органолептическими методами исследования.
Услуги клиники
Наш медицинский центр предлагает общий анализ крови, определение группы крови и резус-фактора, биохимию, тест на пищевую непереносимость ImmunoHealth.
Анализы принимаются с 8:00 до 14:00 в будние дни, с 9:00 до 14:00 в субботу и воскресенье

В уютном и комфортном процедурном кабинете, где прохладно жарким летом и тепло студеной зимой, добрая и очень опытная (попадает в цель с первого раза) процедурная медсестра всегда поможет Вам провести забор материалов для лабораторного обследования по следующим направлениям:
Анализы крови
|
|
|
|
|
|
|
|
|
|
|
|
Анализы мочи
|
|
|
Бактериологические и бактериоскопические исследования
|
|
|
|
|
|
|
ПЦР-диагностика
- заболевания, передающиеся половым путем (ЗППП);
- инфекции (сифилис, СПИД, гепатиты);
- определение антител и антигенов к возбудителям половых инфекций, в т.ч. вирусов
Цитологические и гистологические исследования
Кроме того, постоянно и совсем не больно выполняются внутримышечные, подкожные, внутривенные инъекции и вливания, накожные аллергопробы. Мы не обещаем, что результаты анализов Вам понравятся. Мы обещаем только точность исследования. Результаты анализов могут быть отправлены по электронной почте.
Помните, что только Ваш врач поможет Вам в назначении необходимых исследований!
Подготовка к сдаче анализов крови

Кровь для большинства исследований берется строго натощак, то есть когда между последним приемом пищи и взятием крови проходит не менее 8 ч (желательно - не менее 12 ч). Сок, чай, кофе, тем более с сахаром - тоже еда, это необходимо помнить. Можно пить воду.
За 1-2 дня до обследования желательно исключить из рациона жирное, жареное и алкоголь. Если накануне состоялось застолье - перенесите лабораторное исследование на 1-2 дня. За час до взятия крови воздержитесь от курения.
Перед сдачей крови нужно исключить физическое напряжение (бег, подъем по лестнице), эмоциональное возбуждение. Перед процедурой следует отдохнуть 10-15 минут, успокоиться.
Кровь не следует сдавать сразу после рентгенологического, ультразвукового исследования, массажа, рефлексотерапии или физиотерапевтических процедур.
В разных лабораториях могут применяться разные методы исследования и единицы измерения показателей. Для правильной оценки и сравнения результатов Ваших лабораторных исследований рекомендуется осуществлять их в одной и той же лаборатории, в одно и то же время.
Кровь на анализ сдают до начала приема лекарственных препаратов или не ранее чем через 10-14 дней после их отмены. Для оценки контроля эффективности лечения любыми препаратами целесообразно исследовать кровь спустя 14-21 день после последнего приема препарата. Если вы принимаете лекарства, обязательно предупредите об этом лечащего врача.
Перед сдачей общего анализа крови, последний прием пищи должен быть не ранее, чем за 3 часа до забора крови.
Для определения холестерина, липопротеидов кровь берут после 12-14 часового голодания. За две недели до исследования необходимо отменить препараты, понижающие уровень липидов в крови, если не ставится цель определить гиполипидемический эффект терапии этими препаратами.
Для определения уровня мочевой кислоты в предшествующие исследованию дни необходимо соблюдать диету: отказаться от употребления в пищу богатой пуринами пищи – печени, почек, максимально ограничить в рационе мясо, рыбу, кофе, чай. Противопоказаны интенсивные физические нагрузки.
Сдача крови на гормональное исследование проводится натощак (желательно в утренние часы; при отсутствии такой возможности - спустя 4-5ч после последнего приема пищи в дневные и вечерние часы). Накануне сдачи анализов из рациона следует исключить продукты с высоким содержанием жиров, последний прием пищи не делать обильным.
На результаты гормональных исследований у женщин репродуктивного возраста влияют физиологические факторы, связанные со стадией менструального цикла, поэтому при подготовке к обследованию на половые гормоны следует указать фазу цикла и придерживаться рекомендаций лечащего врача о дне менструального цикла, в который необходимо сдать кровь.
Гормоны репродуктивной системы сдаются строго по дням цикла:
- ЛГ, ФСГ - 3-5 день
- Эстрадиол - 5-7 или 21-23 день цикла
- прогестерон 21-23 день цикла
- пролактин, 17-ОН-прогестерон
- ДГА-сульфат, тестостерон - 7-9 день

Гормоны щитовидной железы, инсулин, С-пептид сдаются независимо от дня цикла.
Перед сдачей крови на стрессовые гормоны (АКТГ, кортизол) необходимо успокоиться, при сдаче крови отвлечься и расслабиться, так как любой стресс вызывает немотивированный выброс этих гормонов в кровь, что повлечет увеличение данного показателя.
Требования к сдаче крови при исследовании на наличие инфекций такие же, как при исследовании гормонального профиля.
Кровь сдается натощак (в утренние часы или спустя 4-5ч после последнего приема пищи в дневные и вечерние часы, причем этот последний прием не должен быть обильным, а продукты с высоким содержанием жиров следует исключить из рациона и накануне сдачи анализа). Результаты исследований на наличие инфекций зависят от периода инфицирования и состояния иммунной системы, поэтому отрицательный результат полностью не исключает инфекции. В сомнительных случаях целесообразно провести повторный анализ спустя 3-5 дней. Исследование крови на наличие антител классов IgG, IgM, IgA к возбудителям инфекций следует проводить не ранее 10-14 дня с момента заболевания, так как выработка антител иммунной системой и появление их диагностического титра начинается в этот срок. На раннем этапе заболевания происходит сероконверсия (отсутствие антител в острый период заболевания).
Перед сдачей крови на вирусные гепатиты за 2 дня до исследования желательно исключить из рациона цитрусовые, оранжевые фрукты и овощи.
Перед сдачей крови на коагулогические исследования необходимо информировать врача о приёме противосвёртывающих лекарств.
Подготовка к сдаче анализов мочи и кала
Правила сбора биоматериала
Сбор мочи пациент проводит самостоятельно (исключение составляют дети и тяжело больные). Для получения достоверных результатов анализа необходимо строгое соблюдение правил инструкции.
Моча здорового человека стерильна, однако при прохождении через мочеиспускательный канал она может загрязняться микрофлорой. Поэтому очень важно проводить правильный забор мочи, как можно тщательнее соблюдая правила гигиены.
До взятия мочи проводится предварительный туалет наружных половых органов:
у женщин - стерильным ватным тампоном с теплой мыльной водой промываются влагалище и губы движением спереди и вниз; затем тщательно промываются теплой водой и высушиваются чистой салфеткой, предварительно проглаженной горячим утюгом.
у мужчин - проводится туалет наружного отверстия мочеиспускательного канала теплой водой с мылом, затем промывается теплой водой и высушивается чистой салфеткой, предварительно тщательно проглаженной.
Нельзя собирать мочу во время менструации. После проведения цистоскопии анализ мочи можно назначать не ранее, чем через 5-7 дней.
Общий клинический анализ мочи. Для общего анализа используют первую утреннюю порцию мочи (нужно, чтобы предыдущее мочеиспускание было не позже, чем в 2 часа ночи). Всю порцию утренней мочи собирают сразу после сна (натощак) при свободном мочеиспускании. Мужчины при мочеиспускании должны полностью оттянуть кожную складку и освободить наружное отверстие мочеиспускательного канала. Женщины должны раздвинуть половые губы. Затем необходимо отлить 40-50 миллилитров от общего объема первой утренней порции мочи в специальный контейнер, который необходимо плотно закрыть крышкой и доставить в лабораторию. Нельзя брать мочу из судна, горшка.
Собранную мочу доставляют в лабораторию сразу. Допускается хранение мочи в холодильнике (при 2o-4oС), но не более 1,5 часов. Пациент сообщает время сбора мочи процедурной сестре.
Сбор суточной мочи. Данная процедура необходима для определения содержания в моче 17-КС, общего белка и альбумина, глюкозы, креатинина, билирубина, кальция, фосфора, натрия, калия. Пациент собирает мочу в течение 24 ч при обычном питьевом режиме (около 1,5 л в сутки). Утром в 6-8 ч он освобождает мочевой пузырь (эту порцию мочи он выливает), а затем в течение суток собирает всю мочу в чистый широкогорлый сосуд из темного стекла с крышкой емкостью не менее 2 л. Последняя порция берется точно в то же время, когда накануне был начат сбор (время начала и конца сбора отмечают). Емкость с мочой необходимо хранить в прохладном месте (оптимально - в холодильнике на нижней полке при 4-8oС), не допуская ее замерзания. По окончании сбора мочи измеряют её объем, мочу тщательно взбалтывают и отливают 50-100 мл в в специальный контейнер, в котором она будет доставляться в лабораторию.
Обязательно указывают объем суточной мочи!
Сбор мочи для исследования по Нечипоренко
Преобладающей по объему должна быть вторая порция, сбор которой проводят в чистую, сухую, бесцветную широкогорлую посуду (не касаясь склянкой тела). Собранную среднюю порцию мочи (20-25 мл) сразу доставляют в лабораторию в специальном контейнере*. Допускается хранение мочи в холодильнике (при 2o-4oС), но не более 1,5 часов. Пациент сообщает время сбора мочи процедурной сестре.
Сбор мочи для исследования по Зимницкому. Пациент остается на обычном режиме питания, но учитывает количество выпитой жидкости за сутки. После опорожнения мочевого пузыря в 6 часов утра через каждые 3 часа в течение суток собирают мочу в отдельные емкости, на которых указывает время сбора или номер порции, всего 8 порций. 1 порция - с 6-00 до 9-00, 2 порция - с 9-00 до 12-00, 3 порция - с 12-00 до 15-00, 4 порция - с 15-00 до 18-00, 5 порция - с 18-00 до 21-00, 6 порция - с 21-00 до 24-00, 7 порция - с 24-00 до 3-00, 8 порция - с 3-00 до 6-00 часов. Все собранное количество мочи в 8 специальных контейнерах* доставляется в лабораторию. Пациент обязательно сообщает процедурной сестре объем суточной мочи!Сбор мочи для микробиологического исследования (посев мочи). Мочу собирают в стерильный контейнер, который пациент получает в лаборатории. Сбор утренней мочи проводится после тщательного туалета наружных половых органов (см. выше). ПЕРВЫЕ 15 мл МОЧИ ДЛЯ АНАЛИЗА НЕ ИСПОЛЬЗУЮТСЯ. ПОСЛЕДУЮЩИЕ 3-10мл. СОБИРАЮТСЯ В СТЕРИЛЬНЫЙ КОНТЕЙНЕР С КРЫШКОЙ. Доставка материала в лабораторию осуществляется в течение 1,5-2 часов после сбора. Допускается хранение мочи в холодильнике не более 3-4 часов. В случае доставки мочи в лабораторию позже указанных сроков результаты посева мочи могут быть недостоверны. СБОР МОЧИ НЕОБХОДИМО ПРОВОДИТЬ ДО НАЧАЛА МЕДИКАМЕНТОЗНОГО ЛЕЧЕНИЯ. Если ставится цель оценить эффект проведенной терапии, то посев мочи производится по окончании курса лечения.
Исследование кала на яйца гельминтов, для обнаружения простейших, возбудителей кишечной группы, ротавирусов. Кал собирают в стерильный контейнер* и доставляют в течение 3 часов после сбора.
Биохимический экспресс анализ кала на дисбактериоз. В специальный контейнер необходимо отобрать 2-4 г. (объем 1-2 чайных ложки) кала и в этот же день доставить в лабораторию. В случае если доставка материала производиться не в день забора, свежесобранные образцы помещают в морозильную камеру и замораживают. Размораживание образцов не допускается.
ВНИМАНИЕ!!! Обязательно указывать тип стула (понос, запор, без особенностей, стул со слабительными).
Кал на копрологию. В специальный контейнер, помещают кал объемом около 2 чайных ложек и доставляют в лабораторию в течение 5 часов. Стул должен быть получен без применения клизм и слабительных.
Микробиологический анализ микрофлоры кишечника с определением антибиотико- и фагочувствительности (дисбактериоз). Для данного исследования необходимо собрать в стерильный контейнер около 2 г. (1 чайная ложка) кала, полученного без применения клизм и слабительных, и доставить в лабораторию не позже 3 часов после сбора.
Исследование кала на скрытую кровь. За три дня до сдачи этого анализа из рациона необходимо исключить мясо, печень, кровяную колбасу и все продукты, содержащие железо (яблоки, болгарский перец, шпинат, белую фасоль, зеленый лук, огурцы и т.д.) Стул должен быть получен без применения клизм и слабительных. Сбор кала осуществляется в специальный контейнер, объемом около 1 чайной ложки. Материал доставляют в лабораторию в течение 5 часов.
Исследование кала на углеводы. В специальный контейнер помещают около 1 столовой ложки кала, полученного без клизм и слабительных. Доставляют в лабораторию в течение 5 часов.
Исследование на энтеробиоз (для выявления тениид и остриц). Для данного иследования биоматериал берется с перианальных складок (вокруг анального отверстия) самим пациентом. Процедура проводится утром сразу после подъема с постели ДО ПРОВЕДЕНИЯ ГИГИЕНИЧЕСКИХ ПРОЦЕДУР, МОЧЕИСПУСКАНИЯ И ДЕФЕКАЦИИ. Ватной палочкой круговыми движениями забирается материал с перианальных складок (где и откладывают яйца выше указанные гельминты), после чего палочку помещают в специальный контейнер (неиспользованный конец ватной палочки удалить). Материал доставляется в лабораторию в течение 3-х часов после сбора.
Исследование грудного молока. Перед сбором материала грудь помыть теплой водой с мылом, вытереть чистым полотенцем, тщательно обработать соски и околососковую область молочных желез ватным тампоном, смоченным 70% этиловым спиртом (каждая железа обрабатывается отдельным тампоном). Первые 10-15 мл сцеженного молока для анализа не используются. Последующие 3-4 мл молока собираются из каждой груди в отдельные контейнеры (правый и левый подписать). Материал доставляется в лабораторию в течение 2-х часов после сбора.
Посев мокроты. Мокрота собирается в стерильный контейнер. Перед откашливанием больной должен почистить зубы и прополоскать рот кипяченой водой. Для улучшения откашливания больному предварительно следует назначить отхаркивающие средства, теплое питье. Материал доставляют в лабораторию в течение часа.
Исследование мазка из зева с определением чувствительности к антибиотикам, на дифтерию, микобактерии туберкулеза, гемолитический стрептококк. Мазок из зева берется строго натощак, перед исследованием нельзя чистить зубы, полоскать рот водой, пить.
Посев спермы. Для более достоверного результата необходимо половое воздержание от 2 до 7 дней. Сперму собирают в стерильный контейнер, который необходимо получить в лаборатории. Утром после сна необходимо помочиться, произвести тщательный туалет наружного отверстия мочеиспускательного канала теплой водой с мылом. Сбор материала производить путем мастурбации, не касаясь стенок контейнера. Анализ собирается до проведения курса антибиотиков или через 2-3 недели после него. Сперму доставить в лабораторию в течение 3 часов после сбора.
Спермограмма

В этот период нельзя принимать алкоголь, лекарственные препараты, посещать баню или сауну, подвергаться воздействию УВЧ. При повторном исследовании желательно устанавливать одинаковые периоды воздержания для снижения колебаний полученного результата. Спермограмма - метод исследования эякулята для оценки его оплодотворяющей способности. При анализе спермы определяют количественные, качественные, морфологические параметры спермы.
Спермограмма включает:
- Физические параметры (объем, цвет, рН, вязкость, скорость разжижения).
- Количественные характеристики (количество сперматозоидов в 1 мл и во всем эякуляте, подвижность).
- Морфологию сперматозоидов (содержание нормальных форм, с патологией), наличие агглютинации и клеток сперматогенеза, а также содержание лейкоцитов, эритроцитов, наличие слизи.
Оценивать оплодотворяющую способность спермы по отдельно взятым параметрам некорректно, необходимо учитывать одновременно все показатели. В качестве нормативных, приняты показатели, рекомендованные Всемирной Организацией Здравоохранения. Даже у одного и того же мужчины в течение года показатели спермы могут значительно изменяться.
При диагностике мужского бесплодия при результатах, отличных от нормы, необходимо через 1-2 недели пересдать спермограмму. С полученными результатами обратиться к андрологу для поиска причин возникшей патологии.
Сбор секрета предстательной железы на посев. Секрет простаты получают в процессе энергичного массажа предстательной железы врачом. Материал собирается в стерильный контейнер после туалета наружного отверстия мочеиспускательного канала теплой водой с мылом.
Профессиональный коллектив врачей и медсестер
Современное диагностическое оборудование и собственная клиническая лаборатория
Международные и отечественные стандарты диагностики и лечения
Справедливая ценовая политика
Цены на услуги
| ПРЕЙСКУРАНТ МЕДИЦИНСКИХ УСЛУГ | |
|---|---|
| (стоимость на медицинские услуги указана в рублях, не облагается НДС) | |
| Наименование | Стоимость |
| НАТАЛИ-МЕД АНАЛИЗЫ>>Биохимия | |
| 3абор крови из вены | 350 |
| АлАТ | 400 |
| АсАТ | 400 |
| Билирубин общий | 400 |
| Билирубин прямой | 400 |
| Глюкоза | 400 |
| Глюкозотолерантный тест | 1,500 |
| Креатинин | 400 |
| Липидный профиль (ЛПНП, ЛПВП, холестерол, триглицериды) риск атеросклероза | 1,600 |
| Мочевая кислота | 400 |
| Мочевина | 400 |
| Общий белок | 400 |
| Триглицериды | 430 |
| Холестерин общий | 400 |
| НАТАЛИ-МЕД АНАЛИЗЫ>>ГЕМОСТАЗИОГРАММА | |
| АЧТВ | 400 |
| Протромбин + МНО | 550 |
| Тромбиновое время | 550 |
| Фибриноген | 500 |
| НАТАЛИ-МЕД АНАЛИЗЫ>>ИФА | |
| 3абор крови из вены | 350 |
| Anti HCV (гепатит С) | 850 |
| HBs Ag (гепатит В) | 600 |
| b-ХГЧ | 750 |
| ВИЧ (антиген + антитела) | 650 |
| Сифилис RPR | 600 |
| Сифилис РПГА | 600 |
| НАТАЛИ-МЕД АНАЛИЗЫ>>Общая кровь,моча,группа крови | |
| Группа крови, резус-фактор | 1,000 |
| Клинический анализ крови (+ СОЭ с лейкоцитарной формулой) | 850 |
| Общий анализ мочи | 600 |
| НИИ ЭПИДЕМИОЛОГИИ (CMD)>>RW, ВИЧ, HBs, HcV | |
| Anti HCV (гепатит С) | 850 |
| HBs Ag (гепатит В) | 600 |
| ВИЧ (антиген + антитела) | 650 |
| Сифилис RPR | 700 |
| Сифилис РПГА | 700 |
| Сифилис РПГА полуколичественный | 700 |
| НИИ ЭПИДЕМИОЛОГИИ (CMD)>>БАКТЕРИОЛОГИЯ | |
| Бактериальный вагиноз с определением антибиотикочувствительности | 1,900 |
| Взятие мазка/соскоба | 400 |
| Диагностика микоплаз.инф. посев(Ureapl.\mykopl/homi),опред колич и чувст к АМП | 2,100 |
| Компл.иссл.на выяв возбуд.мочевой .системы .(Neis/gon.Trich.V,candida) | 2,500 |
| Посев Corynebacterium Diphtheriae мазок из зева или носа (1 локализация) | 1,100 |
| Посев крови на стерильность (10 р.д.) | 2,900 |
| Посев на Neisseria gonorrhoeae с определение чувствительности к АМП | 1,100 |
| Посев на гемолитические стрептококи из зева\носа (1 локализ) | 1,200 |
| Посев на грибы рода Candida с определением чув-ти к антимикотическим препарат. | 1,600 |
| Посев на золотистый стафилококк из зева/носа (1 лок-я) к антимикробным препар. | 1,100 |
| Посев на микоплазму с опр. чувствительности к АМП | 2,000 |
| Посев на трихомонаду НИИ | 1,200 |
| Посев на уреаплазму с опр. чувствительности к АМП | 1,600 |
| Посев на флору с определением чувствительности к основному спектру АМП | 1,600 |
| Посев на флору с определением чувствительности к основному спектру АМП и фагам | 1,850 |
| Посев на флору с определением чувствительности к расширенному спектру АМП | 2,100 |
| Посев с определением чувствительности к расширенному спектру АПМ и фагам | 2,500 |
| НИИ ЭПИДЕМИОЛОГИИ (CMD)>>Биохимия, маркеры, гормоны>>Аутоантитела | |
| Антинуклеарный фактор на клеточной линии HEp-2, полуколичественное определение | 1,550 |
| Антитела к B2 гликопротеину I (IgG) приостанавливается с 12.10.22 | 1,500 |
| Антитела к B2 гликопротеину I (IgM) приостанавливается с 12.10.22 | 1,500 |
| Антитела к двухспиральной ДНК (a-dsDNA) | 1,050 |
| Антитела к инсулину (6 к.д.) | 2,000 |
| Антитела к кардиолипину IgG | 1,350 |
| Антитела к кардиолипину IgM | 1,350 |
| Антитела к микросомальной фракции печени и почек (LKM-1) до 5 к.д. | 1,850 |
| Антитела к митохондриям (AMA-М2) | 1,800 |
| Антитела к односпиральной ДНК (a-ssDNA) | 1,350 |
| Антитела к рецепторам ТТГ (до 6 к.д.) | 1,800 |
| Антитела к тиреопероксидазе | 800 |
| Антитела к трансглутаминазе IgA | 1,700 |
| Антитела к трансглутаминазе IgG | 1,800 |
| Антитела к фосфолипидам | 2,400 |
| Антитела к циклическому цитрулиновому пептиду (АТ к ССР) | 1,700 |
| Антитела к ядерным антигенам (ANA screen) | 1,280 |
| Диагностика целиакии, непереносимость глютена (расширенная) до 6 к.д. | 5,000 |
| Диагностика целиакии, непереносимость глютена до 6 к.д. | 2,950 |
| НИИ ЭПИДЕМИОЛОГИИ (CMD)>>Биохимия, маркеры, гормоны>>Биохимия | |
| Na/ K/ Cl/ ионизированный Ca (2 рабочих дня) | 900 |
| АлАТ | 400 |
| Альбумин | 400 |
| Альфа - амилаза | 500 |
| Амилаза панкреатическая | 550 |
| Антистрептолизин-О | 750 |
| Апо-липопротеин В | 800 |
| АсАТ | 400 |
| Белковые фракции | 850 |
| Билирубин общий | 400 |
| Билирубин прямой | 400 |
| В-12 | 1,200 |
| Витамин D (25 OH) | 3,300 |
| Гамма-ГТ | 400 |
| Глюкоза | 400 |
| Глюкозотелерантный тест | 1,500 |
| Железо | 400 |
| Индекс омега 3 | 5,500 |
| Кальций | 400 |
| Кальций ионизированный | 650 |
| Кислая фосфатаза | 500 |
| Креатинин | 400 |
| Креатинкиназа (КФК) | 600 |
| ЛДГ | 440 |
| ЛДГ 1, 2 фракции | 450 |
| ЛПВП | 450 |
| ЛПНП | 450 |
| Липаза | 600 |
| Липидный профиль (ЛПНП, ЛПВП, холестерол, триглицериды) риск атеросклероза | 1,690 |
| Липопротеин (а) | 1,550 |
| Магний | 450 |
| Медь | 1,050 |
| Миоглобин | 1,400 |
| Молочная кислота (лактат) 4 рабочих дня | 900 |
| Мочевая кислота | 400 |
| Мочевина | 400 |
| НЖСС | 500 |
| ОЖСС | 450 |
| Общий белок | 400 |
| Остеокальцин НИИ | 1,300 |
| Ревматоидный фактор | 700 |
| С-реактивный белок ультрачувствительный (для кардиологии) | 700 |
| Селен | 1,050 |
| Трансферрин | 800 |
| Триглицериды | 400 |
| Ферритин | 900 |
| Фоливая кислота | 1,300 |
| Фосфор | 400 |
| Фракции липопротеинов НЕ ДЕЛАЮТ | 600 |
| Фруктозамин | 1,000 |
| Холестерин общий | 400 |
| Холинэстераза | 450 |
| Церулоплазмин | 750 |
| Цинк (6 р. д.) | 1,000 |
| Щелочная фосфатаза | 400 |
| Эритропоэтин | 1,700 |
| НИИ ЭПИДЕМИОЛОГИИ (CMD)>>Биохимия, маркеры, гормоны>>Гормоны | |
| 17 ОН прогестерон | 950 |
| АКТГ (2-4 к.д.) | 1,100 |
| АМГ (Антимюллеров гормон) до 4 к.д. | 2,600 |
| АТ-ТГ | 800 |
| АТ-ТПО | 800 |
| АФП | 650 |
| Альдостерон | 1,150 |
| Андростендиола Глюкуронид (5 к.д.) | 2,100 |
| Андростендион | 1,750 |
| Антитела к рецепторам ТТГ (7 р. д.) | 1,850 |
| ГСПГ (глобулин, связывающий половой гормон) | 900 |
| Гомоцистеин | 2,100 |
| ДЭА-SO4 | 700 |
| Дигидротестостерон | 1,850 |
| Ингибин В (4 рабочих дня) | 2,100 |
| Инсулин | 1,000 |
| Инсулинорезистентность: инсулин, глюкоза натощак, индекс НОМА | 1,200 |
| Кальцитонин (отправляют со льдом) до 3 к.д. | 1,450 |
| Кортизол | 600 |
| ЛГ | 700 |
| Лептин (до 7 раб.дней) | 1,350 |
| Определение фракций пролактина (пролактин, мономерный пролактин, макропролактин) | 1,450 |
| Паратиреоидный гормон НИИ | 1,100 |
| Прогестерон | 700 |
| Пролактин | 700 |
| С-пептид | 890 |
| СТГ | 900 |
| Свободный тестостерон | 1,450 |
| Т3 общий | 600 |
| Т3 свободный | 600 |
| Т4 общий | 600 |
| Т4 свободный | 650 |
| ТГ (тиреоглобулин) | 1,000 |
| ТТГ | 600 |
| Тестостерон | 700 |
| Тестостерон свободный (до 6 р.д.) | 1,450 |
| ФСГ | 700 |
| Эстрадиол | 700 |
| Эстриол свободный | 1,900 |
| НИИ ЭПИДЕМИОЛОГИИ (CMD)>>Биохимия, маркеры, гормоны>>Маркеры остеопороза | |
| P1NP | 3,100 |
| b-CrossLaps | 1,500 |
| Кальцитонин (отправляют со льдом) | 1,400 |
| Остеокальцин | 1,300 |
| НИИ ЭПИДЕМИОЛОГИИ (CMD)>>Биохимия, маркеры, гормоны>>Онкомаркеры | |
| Cyfra 21-1 (фрагмент цитокератина) | 1,500 |
| NSE (нейро-специфическая енолаза) | 2,050 |
| SCC | 2,300 |
| UBC (антиген рака мочевого пузыря) до 4 к.д. | 2,900 |
| b-ХГЧ | 700 |
| b-ХГЧ свободный | 1,500 |
| АФП | 650 |
| Белок S 100 (до 5 к.д.) | 2,800 |
| В-2-микроглобулин | 1,500 |
| Оценка риска рака яичников до менопаузы PREM ROMA (НЕ4, СА125, %) | 2,250 |
| Оценка риска рака яичников после менопаузы POST ROMA (НЕ4, СА125, %) | 2,250 |
| ПСА общий | 750 |
| ПСА общий/свободный | 1,400 |
| Пренатальный скрининг 1 (ПАПП+ХГЧ) IV | 3,600 |
| Пренатальный скрининг 2 (АФП+ХГЧ+свобоный эстриол) IV | 5,200 |
| РАРР-А (ассоциированный с беременностью плазменный белок А) | 1,200 |
| РЭА | 1,000 |
| СА 125 | 1,000 |
| СА 15-3 | 1,000 |
| СА 19-9 | 1,000 |
| СА 242 (до 4 к.д.) | 1,100 |
| СА 72-4 | 1,550 |
| НИИ ЭПИДЕМИОЛОГИИ (CMD)>>ГЕНЕТИЧЕСКИЕ ИССЛЕДОВАНИЯ | |
| Типирование генов HLA II класса (локус DRB1) предрасп. к аутоимм. заб. 5-12 к.д | 4,200 |
| Типирование генов HLA II класса обслед. пар на совместимость 5-12 к.д | 19,300 |
| Цитогенетическое исследование (кариотип) - срок изготовления 12 - 24 к.д. | 8,700 |
| Цитогенетическое исследование хориона при неразвивающейся беременности до 24 к.д | 19,000 |
| НИИ ЭПИДЕМИОЛОГИИ (CMD)>>Гематология, группа крови | |
| Анализ крови на ретикулоциты | 500 |
| Антиген системы Kell (K) | 1,150 |
| Антитела к антигенам эритроцитов (титр) | 1,100 |
| Гликозилированный гемоглобин | 900 |
| Группа крови, резус-фактор | 1,000 |
| Клинический анализ крови (+ СОЭ с лейкоцитарной формулой) | 850 |
| НИИ ЭПИДЕМИОЛОГИИ (CMD)>>Гемостазиограмма | |
| АЧТВ | 400 |
| Анти Rh(титр) | 1,000 |
| Антитромбин III | 650 |
| Волчаночный антикоагулянт | 1,200 |
| Д-димер | 1,700 |
| Про-натрийуретический N-концевой пептид B-типа (до 5 к.д.) | 3,900 |
| Протеин S свободный (до 8 к.д.) с 27.08.22 | 2,800 |
| Протеин С (до 8 к.д.) | 2,300 |
| Протромбин + МНО | 500 |
| Тромбиновое время | 500 |
| Фибриноген | 500 |
| НИИ ЭПИДЕМИОЛОГИИ (CMD)>>ДОПОЛНИТЕЛЬНЫЕ ТЕСТЫ | |
| anti-Salmonella A,B,C1,C2,D,E | 900 |
| Агрегац факторы сист свертывания крови. Заключение генетика (10 р.д.) | 1,000 |
| Агрегационные факторы системы свертывания крови (10 р.д.) НЕ ДЕЛАЮТ | 5,600 |
| Анти - псевдотуберкулез и анти - иерсиниоз НИИ | 1,450 |
| Антиспермальные АТ Ig G (эякулят) mar-test | 2,100 |
| Антиспермальнын АТ Ig A (эякулят) mar-test | 2,100 |
| Антитела к фосфолипидам | 2,300 |
| ДНК Varicella-Zoster virus (ПЦР) | 500 |
| Коклюш: anti-Bordetella pertussis и parapertussis (РПГА) | 900 |
| Консультативный пересмотр готовых гистол.препаратов(блок+стекло) до 5 к.д. | 2,100 |
| Наследствен рак молочной железы и яичников. Заключен генетика (10 р.д.)НЕ ДЕЛАЮТ | 1,000 |
| Наследственный рак молочной железы и яичников (10 р.д.) заполнять анкету врач | 5,000 |
| Плазмен факторы сист сверт крови. Заключен генетика (10 р.д.) НЕ ДЕЛАЮТ | 1,000 |
| Плазменные факторы системы свертывания крови (10 р.д.) | 5,100 |
| Промежуточные метаболиты катехоламинов (моча) | 3,100 |
| РНК Тест система NASBA Trichomonas vaginallis НЕ ДЕЛАЮТ | 1,500 |
| РНК диагност гонореи Neisseria gonorrhoea (тест-система NASBA): соскоб НЕ ДЕЛАЮТ | 1,500 |
| РНК диагност хламидий Chlamidia trachomatis (тест-сист NASBA): соскобНЕ ДЕЛАЮТ | 1,500 |
| РНК диагностика микоплазмы NASBA соскоб НЕ ДЕЛАЮТ | 1,500 |
| Система свертывания крови. Заключение генетика (10 р.д.) | 1,200 |
| Система свертывания крови. Исследование полиморфизмов в генах (10 р.д.) | 2,500 |
| Цитологическая диагностика поражений кожи | 3,200 |
| Шигеллы: Anti - Shigella flexneri 1-V, V1 и Anti - Shigella sonnei (РПГА) | 1,350 |
| НИИ ЭПИДЕМИОЛОГИИ (CMD)>>ИММУНОЛОГИЯ И АЛЛЕРГОЛОГИЯ | |
| Иммуноглобулин Е | 750 |
| Иммуноглобулины А, М, G (4-7 к.д.) | 1,350 |
| Интерфероновый статус без опред. чув-ти к пр-там (7-12 к.д.) (пн-чт!) | 5,500 |
| Интерфероновый статус: тройной тест НЕ ДЕЛАЮТ | 0 |
| Исследование субпопуляций лимфоцитов, min панель (4-7 к.д.) (вск-чт!) | 4,900 |
| Исследование субпопуляций лимфоцитов, расш.панель(4-7 к.д.) (вск-чт!) | 9,500 |
| НСТ-тест (4-7 к.д.) (забор пн-чт!) | 1,050 |
| С3 компонент (4-7 к.д.) | 700 |
| С4 компонент (4-7 к.д.) | 700 |
| Циркулирующие иммунные комплексы (ЦИК) (4-7 к.д.) | 1,300 |
| Эозинофильный катионный белок (до 5 р.д.) | 1,300 |
| НИИ ЭПИДЕМИОЛОГИИ (CMD)>>Исследование мочи и кала | |
| 2-х стаканная проба | 600 |
| 3-х стаканная проба | 800 |
| Анализ кала на яйца гельминтов и простейшие | 600 |
| Анализ мочи по Зимницкому | 800 |
| Анализ мочи по Нечипоренко | 600 |
| Антинген клостридии токсины А и В (качеств) КАЛ | 1,700 |
| Гельмо-скрин. Выявление ДНК гельминов методом ПЦР | 2,400 |
| Дисбактериоз с определением чувствительности к фагам (до 10 р.д) | 2,400 |
| Исследование мочи и мокроты на атипичные клетки (цитология) 4-7 к.д. | 1,100 |
| Исследование соскоба на энтеробиоз | 600 |
| Кал на скрытую кровь (без диеты) | 600 |
| Кал на углеводы | 800 |
| Микроальбумин (суточная моча) | 600 |
| Общий анализ кала (копрограмма) | 700 |
| Общий анализ мочи | 600 |
| Посев кала на Shigella spp., Salmonella spp (перед госпитализацией, мед. обслед) | 990 |
| Проба Реберга (моча суточная + креатенин крови) | 600 |
| Химический состав мочевого камня (спектральный анализ) до 6 р. д. | 5,700 |
| НИИ ЭПИДЕМИОЛОГИИ (CMD)>>Маркеры инфекций (ИФА) | |
| Anti-Aspergillus Ig G (кач) | 850 |
| Anti-EBV-EBNA Ig G | 1,000 |
| anti-EBV-EA Ig G | 1,000 |
| anti-Yersinia enterocjlitica | 1,500 |
| Аnti-Brucella species PA(а/т к возб.бруцеллеза)качественное определение | 800 |
| Анти-Трепонема Паллидум (суммарные) | 800 |
| Анти-Уреаплазма IgG | 900 |
| Анти-Уреаплазма IgM | 900 |
| Анти-Уреаплазма IgА | 900 |
| Антитела к аскаридам IgG (до 4 к.д.) | 1,135 |
| Антитела к дифтерии (до 4 к.д.) | 1,050 |
| Антитела к коклюшу и паракоклюшу (anti-Bordetella pertussis, parapertussis) | 1,350 |
| Антитела к лямблиям Ig G, IgM, IgA сумм (п\колич) | 900 |
| Антитела к лямблиям Ig M (п\колич) | 800 |
| Антитела к описторхам | 1,050 |
| Антитела к парвовирусу В-19 Ig M | 1,600 |
| Антитела к сальмонелле A, B, C, D, E | 980 |
| Антитела к столбняку (anti-Tetanus toxoid Ig G) | 1,150 |
| Антитела к токсокарам | 750 |
| Антитела к трихинеллам | 750 |
| Антитела к шигеллам | 1,400 |
| Антитела к шистосомам Ig G (п.кол) | 1,200 |
| Антитела к эхинококку | 950 |
| Антитела кандида Ig G кач | 900 |
| Антитела коклюш IgA | 1,100 |
| Антитела коклюш IgG | 1,050 |
| Антитела коклюш IgM | 1,100 |
| Боррелиоз Anti-Borrelia Ig G (кач.) | 1,000 |
| Боррелиоз Anti-Borrelia Ig M (колич.) | 1,300 |
| Брюшной тиф (2-4 к. д.) | 800 |
| Вирус Эпштейн-Барр Anti-EBV-VCA Ig G | 950 |
| Вирус Эпштейн-Барр Anti-EBV-VCA Ig M | 850 |
| НИИ ЭПИДЕМИОЛОГИИ (CMD)>>Маркеры инфекций (ПЦР) | |
| Вирус Эпштейн-Барр ДНК EBV (колич.) | 700 |
| НИИ ЭПИДЕМИОЛОГИИ (CMD)>>Маркеры инфекций (ИФА) | |
| Вирус ветряной оспы (VZV) Ig M | 1,100 |
| Вирус ветряной оспы антитела anti-VZV Ig G полукол. | 1,000 |
| Вирус кори Anti-Measles virus Ig G | 1,000 |
| Вирус кори Anti-Measles virus Ig M | 1,050 |
| Вирус краснухи Anti-Rubella virus Ig G количественный | 750 |
| Вирус краснухи Anti-Rubella virus Ig M | 950 |
| Вирус краснухи anti-Rubella авидность | 1,200 |
| Вирус паротита Ig G | 950 |
| Вирус паротита Ig M | 1,000 |
| Возбудитель сифилиса (Treponema pallidum), суммарное определение антител класса | 800 |
| Гепатит D Anti HDV Ig M | 1,000 |
| Гепатит D Anti HDV суммарный | 980 |
| НИИ ЭПИДЕМИОЛОГИИ (CMD)>>Маркеры инфекций (ПЦР) | |
| Гепатит D РНК HDV( 4раб дня) | 1,200 |
| Гепатит G РНК HGV | 1,200 |
| НИИ ЭПИДЕМИОЛОГИИ (CMD)>>Маркеры инфекций (ИФА) | |
| Гепатит А anti-HAV IgG | 900 |
| Гепатит А anti-HAV IgM | 1,100 |
| НИИ ЭПИДЕМИОЛОГИИ (CMD)>>Маркеры инфекций (ПЦР) | |
| Гепатит А РНК HAV | 1,200 |
| НИИ ЭПИДЕМИОЛОГИИ (CMD)>>Маркеры инфекций (ИФА) | |
| Гепатит В (Hepatitis B Virus), колич. определение поверхностного антигена | 1,650 |
| Гепатит В Anti HBs количественный | 1,600 |
| Гепатит В Anti-HBc Ig M | 1,050 |
| Гепатит В Anti-HBcore(cуммар) | 800 |
| Гепатит В Anti-HBe | 950 |
| Гепатит В HBeAg | 950 |
| НИИ ЭПИДЕМИОЛОГИИ (CMD)>>Маркеры инфекций (ПЦР) | |
| Гепатит В ДНК HBV качеств.( 4 раб дня) | 800 |
| Гепатит В ДНК HBV количественный 10 дней | 4,400 |
| НИИ ЭПИДЕМИОЛОГИИ (CMD)>>Маркеры инфекций (ИФА) | |
| Гепатит В НВsAg | 550 |
| Гепатит С (HCV) | 750 |
| Гепатит С Anti HCV(суммарн) | 800 |
| Гепатит С Anti HСV lg M | 800 |
| НИИ ЭПИДЕМИОЛОГИИ (CMD)>>Маркеры инфекций (ПЦР) | |
| Гепатит С PHK HCV(типы 1 2 3 ) не делают | 2,400 |
| Гепатит С РНК HCV генотип (до 5 к.д.) | 2,800 |
| Гепатит С РНК HCV качеств | 950 |
| Гепатит С РНК HCV количественный 10 дней | 3,800 |
| НИИ ЭПИДЕМИОЛОГИИ (CMD)>>Маркеры инфекций (ИФА) | |
| Герпес Anti-HSV 1 типа Ig G количественный | 850 |
| Герпес Anti-HSV 1, 2 типов Ig G | 800 |
| Герпес Anti-HSV 1, 2 типов Ig M | 800 |
| Герпес Anti-HSV 2 типа Ig G | 800 |
| Герпес Anti-HНV 6 типа Ig G | 950 |
| Герпес АВИДНОСТЬ аnti-HSV 1, 2 типа IgG(п.кол) | 950 |
| НИИ ЭПИДЕМИОЛОГИИ (CMD)>>Маркеры инфекций (ПЦР) | |
| Герпес ДНК HSV 1, 2 типа | 600 |
| Герпес ДНК HSV 6 типа | 600 |
| ДНК Cytomegalovirus/ Epstein-Barr virus/ Human herpes virus VI (кол.) до 3 к.д. | 1,300 |
| ДНК Enterovirus (качественный) | 1,750 |
| ДНК Herpes simplex virus 1/2 (кач) | 550 |
| ДНК Herpes simplex virus I/II типа/ ДНК Cytomegalovirus (кач.) до 3 к. д. | 950 |
| ДНК Listeria monocytogenes (5 рабочих дней) | 650 |
| ДНК Parvovirus B19 (количественный) | 800 |
| ДНК Varicella-Zoster virus (кач.) кровь | 600 |
| ДНК ВИЧ качественный | 3,300 |
| Диагностика вирусных инфекций дыхательных путей (грипп и ОРВИ) | 2,600 |
| Другие инфекции ДНК Brucella Species | 14,500 |
| НИИ ЭПИДЕМИОЛОГИИ (CMD)>>Маркеры инфекций (ИФА) | |
| Клещевой энцефалит anti-TBE Ig G (кол.) до 4 р.д. | 900 |
| Клещевой энцефалит anti-TBE Ig M (п.кол.) до 4 р.д. | 900 |
| Микоплазмоз Anti-Mycoplasma hominis Ig A | 950 |
| Микоплазмоз Anti-Mycoplasma hominis Ig G | 800 |
| Микоплазмоз Anti-Mycoplasma hominis Ig M | 700 |
| Микоплазмоз Anti-Mycoplasma pneumoniae Ig A количественный | 850 |
| Микоплазмоз Anti-Mycoplasma pneumoniae Ig G количественный | 850 |
| Микоплазмоз Anti-Mycoplasma pneumoniae Ig M | 850 |
| Псевдотуберкулез и иерсинеоз | 1,500 |
| Псевдотуберкулез и иерсиниоз | 1,500 |
| НИИ ЭПИДЕМИОЛОГИИ (CMD)>>Маркеры инфекций (ПЦР) | |
| РНК ВИЧ количественный | 7,700 |
| НИИ ЭПИДЕМИОЛОГИИ (CMD)>>Маркеры инфекций (ИФА) | |
| Сифилис Ig M+Ig G сумм. | 800 |
| Сифилис RPR (RW) | 500 |
| Сифилис TPHA (РПГА) | 700 |
| Сифилис TPHA (РПГА) полуколичественный | 700 |
| Токсоплазмоз Anti-T.gondii Ig G количественный | 750 |
| Токсоплазмоз Anti-T.gondii Ig M | 900 |
| Токсоплазмоз АВИДНОСТЬ anti-T.gondif | 1,350 |
| Хеликобактер Пилори Anti-H. pylori Ig A | 1,050 |
| Хеликобактер Пилори Anti-H. pylori Ig G | 850 |
| Хламидиоз Anti-Chl. pneumoniae Ig A | 850 |
| Хламидиоз Anti-Chl. pneumoniae Ig G | 850 |
| Хламидиоз Anti-Chl. pneumoniae IgM | 800 |
| Хламидиоз Anti-Chl. trachomatis Ig M | 750 |
| Хламидиоз Anti-Chl. trahomatis Ig A полуколичественный | 850 |
| Хламидиоз Anti-Chl. trahomatis Ig G полуколичественный | 850 |
| Цитомегаловирус Anti - CMV Ig G авидность | 1,450 |
| Цитомегаловирус Anti - CMV Ig G количественный | 750 |
| Цитомегаловирус Anti - CMV Ig M | 900 |
| НИИ ЭПИДЕМИОЛОГИИ (CMD)>>Маркеры инфекций (ПЦР) | |
| Цитомегаловирус ДНК CMV ( колич.) | 650 |
| НИИ ЭПИДЕМИОЛОГИИ (CMD)>>ПРЕНАТАЛЬНЫЙ СКРИНИНГ | |
| Прен.скрининг 1 трим. с расчетом риска преэклампсии (Life Cycle Delfia) 4 к. д. | 7,400 |
| Прен.скрининг 2 трим., риск хромосом. аномалий плода | 5,500 |
| Расчет риска ранней и поздней преэклампсии 1 триместра беременности (PAPP-A+PLG) | 5,900 |
| Наименование | Стоимость |
| ИНВИТРО>>RW, ВИЧ, HbS, HCV | |
| Anti HCV (гепатит С) | 850 |
| Anti- HAV IgG (антитела класс IgG к вирусу гепатита А) | 890 |
| HBs Ag (гепатит В) | 600 |
| ВИЧ (антиген + антитела) | 650 |
| Вирус гепатита С определение РНК качест, | 1,000 |
| Иммуноблот рекомбинантный, АТ к вирусу гепатита С Ig G | 3,300 |
| Сифилис RPR | 800 |
| Сифилис РПГА | 800 |
| ИНВИТРО>>БИОХИМИЯ | |
| 1- ый изофермент ЛДГ (a-HBDH) | 350 |
| C-реактивный белок | 650 |
| Na/ K/ Cl | 650 |
| АЦЦП (антитела к циклическому цитруллиновому пептиду) | 1,900 |
| АлАТ | 400 |
| Альбумин | 450 |
| Альфа-2-макроглобулин | 850 |
| Амилаза | 500 |
| Амилаза панкреатическая | 550 |
| Апо-лиипопротеин В | 800 |
| АсАТ | 400 |
| Асл-О | 750 |
| Белковые фракции | 600 |
| Билирубин общий | 400 |
| Билирубин прямой | 400 |
| Витамин D (25 ОН) | 3,300 |
| Витамин В 12 | 1,200 |
| Гамма-ГТ | 400 |
| Гликозированный гемоглобин (HbA1C) | 900 |
| Глюкоза | 400 |
| Железо | 400 |
| Кальций | 400 |
| Кальций ионизированный | 650 |
| Клубочковая фильтрация (расчет СКФ) | 850 |
| Креатинин | 400 |
| Креатинкиназа | 600 |
| Креатинкиназа МВ | 900 |
| ЛДГ | 440 |
| Липаза | 600 |
| Липидный профиль (ЛПНП, ЛПВП, холестерол, триглицериды) риск атерослкроза | 1,690 |
| Магний | 450 |
| Миоглобин | 1,400 |
| Мочевая кислота | 400 |
| Мочевина | 400 |
| Общий белок | 400 |
| Остеокальцин | 1,300 |
| Панкреатическая эластаза (кал) | 3,400 |
| Ревматоидный фактор | 700 |
| С-Реактивный белок (чувствительный) | 700 |
| Трансферрин | 800 |
| Триглицериды | 400 |
| Тропонин I | 1,600 |
| Ферритин | 900 |
| Фолиевая кислота | 1,300 |
| Фосфатаза кислая | 500 |
| Фосфор | 400 |
| Фруктозамин | 1,000 |
| Холестерин общий | 400 |
| Холинэстераза | 450 |
| Щелочная фосфотаза | 400 |
| Эритропоэтин | 1,800 |
| в-Cross laps | 1,600 |
| ИНВИТРО>>ГОРМОНЫ | |
| 17 ОН прогестерон | 1,250 |
| PAPP-A | 1,200 |
| АКТГ | 1,200 |
| АТ-ТГ | 900 |
| АТ-ТПО (микросомальный) | 850 |
| Альдостерон | 1,200 |
| Альдостерон-рениновое соотношение | 2,250 |
| Андростендиола Глюкуронид (12 рабочих дней) | 1,950 |
| Андростендион (до 3 р. д.) | 1,850 |
| Анти-Мюллеров Гормон (5 рабочих дней ) | 1,950 |
| Антитела к рецепторам ТТГ (7 рабочих дней) | 2,100 |
| ГСПГ (берется СТРОГО с тестостероном) | 1,050 |
| Гомоцистеин | 2,500 |
| ДЭА-SO4 | 750 |
| Дигидротестостерон | 1,950 |
| Ингибин В (5 рабочих дней) | 1,850 |
| Инсулин | 1,050 |
| Инсулиноподобный фактор роста-1 (ИФР-1), соматомедин-1 (1 день) | 1,850 |
| Кальцитонин (отправляют со льдом) | 1,700 |
| Кортизол | 750 |
| Кортизол слюны | 1,100 |
| ЛГ | 790 |
| Лептин (до 7 раб.дней) | 1,450 |
| Макропролактин (берется СТРОГО с пролактином) | 1,700 |
| Паратгормон | 1,300 |
| Прогестерон | 750 |
| Прокальцитонин | 3,250 |
| Пролактин | 800 |
| Ренин | 1,450 |
| С-пептид | 900 |
| СТГ | 1,000 |
| Соматомедин -С | 1,850 |
| Т3 | 740 |
| Т3 свободный | 740 |
| Т4 | 740 |
| Т4 свободный | 740 |
| ТТГ | 690 |
| Тестостерон | 750 |
| Тестостерон свободный | 1,700 |
| Тиреоглобулин (до 3 р.д.) | 1,150 |
| ФСГ | 790 |
| Эстрадиол | 750 |
| Эстриол свободный | 1,000 |
| ИНВИТРО>>ГРУППА КРОВИ, ГЕМОСТАЗ | |
| Rh (C,E,c,e), Kell (антигены эритроцитов) | 700 |
| АЧТВ | 400 |
| Анти-Rh (титр) | 650 |
| Антитромбин III | 750 |
| Волчаночный антикоагулянт | 1,350 |
| Группа крови, резус-фактор | 1,000 |
| Д-димер | 2,000 |
| Клинический анализ крови (+ СОЭ с лейкоцитарной формулой) | 850 |
| Подсчет количества ретикулоцитов | 490 |
| Протеин S (до 7 р.д.) | 3,500 |
| Протеин С (до 7 р.д.) | 2,600 |
| Протромбин + МНО | 540 |
| Тромбиновое время | 550 |
| Фибриноген | 500 |
| ИНВИТРО>>ДИСБАКТЕРИОЗ | |
| Дисбактериоз кишечника | 2,300 |
| Остр кишечные инфекции. Определ РНК в кале:Ротавир А, Астровир, Норовируc GI,GII | 1,650 |
| Посев на клостридии | 1,600 |
| Посев на патогенную кишечную группу и определение чувствит. к антибиотикам | 1,450 |
| ИНВИТРО>>ДОПОЛНИТЕЛЬНЫЕ ТЕСТЫ | |
| Ig A | 550 |
| Ig G | 550 |
| Ig M | 550 |
| b-Cross lapc | 1,600 |
| А Т к GAD ВРЕМЕННО НЕ ДЕЛАЮТ | 1,760 |
| АПФ (диагностика саркоидоза) активн. антиотензин-превращ.фермента (до 11 р.д.) | 2,750 |
| Альдостерон (6 р. д.) | 1,320 |
| Анализ кала на яйца гельминтов методом PARASEP | 700 |
| Антинейтрофильные цитоплазматические антитела IgG (до 11 р.д.) | 3,740 |
| Антинуклеарные антитела IgG | 1,550 |
| Антиспермальные антитела (в крови) срок изготовления 11 раб. дней | 1,750 |
| Антитела к ретикулину ARA | 1,800 |
| Антитела к 2-спиральной ДНК (нативной) IgG | 1,500 |
| Антитела к бета клеткам (ICA) поджелуд. IgG | 1,900 |
| Антитела к бета-2-гликопротеину 1, суммарные IgG, IgA, IgM (до 8 р.д.) | 1,490 |
| Антитела к гладкой мускулатуре (11 раб. дней) | 2,600 |
| Антитела к инсулину (IAA) IgG | 1,350 |
| Антитела к кардиолипину скрининг IgA, lgM. lgG (до 8 р.д.) | 1,540 |
| Антитела к латексу | 800 |
| Антитела к петидам глиатилина DGP, Ig A | 1,450 |
| Антитела к сердечной мускулатуре (8 раб.дней) | 1,550 |
| Антитела к сердечной мускулатуре (миокарду) Ig G (кардиомиоцитам) 9 раб.дней | 1,550 |
| Антитела к стероидпродуцирующим клеткам надпочечника, сумм. IgA,IgM,IgG 11 р.д. | 1,650 |
| Антитела к тромбоцитам Ig G, непрямой тест | 3,900 |
| Антитела к фосфолипидам IgM/IgG (до 3 р.д.) | 1,450 |
| Антитела к цитоплазме нейтрофилов ANCA IgG | 3,400 |
| Антитела класса Ig A к тканевой трансглютаминазе | 1,450 |
| Антитела класса Ig G к тканевой трансглютминазе | 1,400 |
| Бета-лактоглобулин, IgE (4 р.д.) | 800 |
| Бета-лактоглобулин, IgG (4 р.д.) | 800 |
| Взятие мазка/соскоба | 300 |
| Висмут (волосы) до 6 р. д. | 600 |
| Витамин В7 (Биотин) | 2,800 |
| Витамин Е | 2,850 |
| Вредные привычки ( до 4-х раб дней) | 4,300 |
| Гастрин | 2,150 |
| Глюкозо-6-фосфатдегидрогенеза эритроцитов, активность (по ПТ не берут) | 3,750 |
| Глюкозотолерантный тест | 1,500 |
| Дигидротестостерон | 1,950 |
| Иммуногистохимический скрининг рака ш/м с антителами к p16, Ki-67(парафин блок) | 10,050 |
| Индивидуальный аллерген | 1,050 |
| Индивидуальный аллерген животных | 950 |
| Индивидуальный аллерген животных (собака) | 800 |
| Интерлейкин 10 (до 5 р.д.) | 2,600 |
| Интерлейкин 6 | 2,540 |
| Интерлейкин 8 (до 5 р.д.) | 2,600 |
| Исследование интерферонового статуса (интерфероны альфа и гамма) | 6,900 |
| Исследование почечного камня (9 рабочих дней) Рентгеновский способ. | 5,300 |
| Кальций, корректированный по альбумину | 800 |
| Кандида определение ДНК (ПЦР) кожа | 700 |
| Кандида определение ДНК (ПЦР) ротоглотка | 700 |
| Кандида оределение ДНК (ПЦР) анус | 700 |
| Катехоламины в плазме (адреналин, норадреналин, дофамин) 5 р.д. | 3,300 |
| Клещ Dermatophagoides pteronyssinus IgE (D1) (клещ домашней пыли) | 1,200 |
| Консультация гистологических препаратов (1 стекло+1парафиновый блок) | 1,550 |
| Молекулярно-генетическое исследование HLA-B27 (болезнь Бехтерева) до 5 р. д. | 2,800 |
| Молоко коровье, IgE | 800 |
| Молоко коровье, IgG (4 р.д.) | 800 |
| Наследственные случаи рака молочной железы и/или яичников CHEK2, NBS1 (11 дн) | 5,400 |
| Неинвазивный перинатальный тест(НИПТ Т21) до 10 раб. дней. | 26,000 |
| Общий IgE | 850 |
| Омега-3 индекс | 5,500 |
| Определение мутаций в генах BRCA1, BRCA2 методом секвенирования NGS (до 22 дней) | 42,800 |
| Определение пола плода (Y-хромосома) С 10 НЕДЕЛИ! (до 7 р.д.) | 6,650 |
| Острые кишеч.инфекции.ПЦРскрин(.8 бакт.и вирус.возбуд кишеч.инф) до 8 к д (КАЛ) | 3,300 |
| Оценка андрогенного статуса (гинекология) | 3,100 |
| Панель аллергенов деревьев: ольха. лещина об., ива, береза, дуб | 2,400 |
| Панель аллергенов сорной травы: полынь, подорожник.амброзия,поташник | 2,400 |
| Панель аллергенов травы: колосок, рожь, тимофеевка, бухарник | 2,400 |
| Панель респираторные аллергены скрининг | 10,900 |
| Посев на анеэробную флору с определен чувст к АБ | 2,100 |
| Посев на бетта-гемолитич.стрептококк группы В(S.agalactiae) с определен. чувствс | 1,700 |
| Посев отделяемого половых органов на микрофлору с опред чувст к антимикробн преп | 1,650 |
| Профиль "Воспалительные миокардиопатии" (а/т к миокарду и митохондриям) | 3,200 |
| Профиль Проблемная кожа (комплексное исследование) | 22,500 |
| Профиль Усиленное выпадение волос | 15,500 |
| Ренин | 1,500 |
| Свободный кортизол ( материал - моча ) | 1,250 |
| Серотонин | 3,050 |
| Синдром Жильбера ген UGT1A1 - 10 рабочих дней (отправляется с анкетой) | 4,500 |
| Скрытая кровь в кале, количественный иммунохимический метод FOB Gold | 1,450 |
| Соматомедин-С | 1,850 |
| Тимофеевка пыльца IgE (до 4 р.д.) | 1,300 |
| Тканевая трансглутаминаза Ig A и G | 1,900 |
| Циркулирующие иммунные комплексы (ЦИК) (до 8 р.д.) | 1,000 |
| Эозинофильный катионный белок (до 6 р.д.) | 1,500 |
| Яйца (белок), IgG (4 р.д.) | 550 |
| Яйца (желток), IgG (4 р.д) | 550 |
| скрининг аллергенов плесень IgG | 2,400 |
| ИНВИТРО>>ИНФЕКЦИИ (КРОВЬ) | |
| anti-EBV IgA VCA (капс. бел.) | 1,050 |
| anti-EBV IgG EA (ранн. бел.) | 1,000 |
| anti-EBV IgG EBNA (яд. бел.) | 850 |
| anti-EBV IgM VCA (капс. бел.) | 0 |
| Антитела к Глиадину G | 1,250 |
| Антитела к Глиадину А | 1,250 |
| Антитела к аскаридам G | 1,250 |
| Антитела к вирусу герпеса Варицелла /Зостер IgM | 1,150 |
| Антитела к вирусу герпеса Варицелла/Зостер IgG | 1,050 |
| Антитела к токсокаре Ig G | 770 |
| Антитела класса Ig G к вирусу гепатита А (anti-HAV Ig G) кач. | 900 |
| Антитела класса IgG к Bordetella pertussis (коклюш) до 4 р. д. | 1,150 |
| Антитела класса IgM к Bordetella pertussis (коклюш) до 4 р. д. | 1,150 |
| Антитела суммарные IgM+IgG+IgA к Mycobacterium tuberculosis | 2,200 |
| Боррелиоз ani-Borrelia burgdorferi Ig G (кол.) | 1,050 |
| Боррелиоз ani-Borrelia burgdorferi Ig M (кол.) | 1,050 |
| Вирус гепатит ТТ | 0 |
| Вирус гепатита С,опред РНК качественный анализ | 1,150 |
| Гепатит А (anti-HAV) IgM | 1,250 |
| Гепатит В HBe-антиген (HBeAg) кач. | 1,000 |
| Гепатит В антитела к HBe-антигену (anti-HBe) кач. | 900 |
| Гепатит В антитела к HBs-антигену (колич.) | 1,000 |
| Гепатит В антитела класса IgM к НВ-core (anti-HB core IgM) кач. | 1,150 |
| Гепатит В антитела классов IgM + IgG к HB-core (anti-HB core total) кач. | 900 |
| Герпес anti HSV АВИДНОСТЬ (7 рабочих дней) | 940 |
| Герпес anti HSV Ig M (1-2 типа ) | 850 |
| Герпес anti-HSV Ig G (1-2 типа ) | 950 |
| Герпес ДНК HSV 6 типа (ПЦР) | 650 |
| ДНК Listeria monocytogenes (5 рабочих дней) | 650 |
| Клещевой энцефалит антитела Ig G (кол.) до 6 р.д | 950 |
| Клещевой энцефалит антитела Ig M (кач.) до 4 р.д | 950 |
| Корь anti- Measles Ig G(кол.) | 1,200 |
| Краснуха anti-Rubella Ig G | 750 |
| Краснуха anti-Rubella Ig M | 950 |
| Стрептоккоковая инфекция,определение ДНК | 950 |
| Токсоплазма anti-Toxo Ig G | 750 |
| Токсоплазма anti-Toxo Ig M | 1,000 |
| Хеликобактер (Helicobacter pylori) Ig G | 900 |
| Хеликобактер (Helicobakter pylori) Ig M | 1,150 |
| Хламидиоз anti Chlamydia trachomatis Ig G | 850 |
| Хламидиоз anti-Chlamydia trachomatis Ig A | 850 |
| Цитомегаловирус anti-CMV Ig G | 850 |
| Цитомегаловирус anti-CMV Ig M | 1,000 |
| ИНВИТРО>>МИКРОЭЛЕМЕНТЫ В КРОВИ | |
| Кадмий (Cadmium, blood; Cd) | 1,200 |
| Кобальт (Cobalt, blood; Co) | 1,200 |
| Марганец (Manganese, blood; Mn) | 1,200 |
| Медь (Copper, blood; Cu) (до 6 р. д. ) | 1,200 |
| Мышьяк (Arsenis, serum; As) (сыворотка крови) | 1,200 |
| Никель (Nickel, blood; Ni) | 1,200 |
| Ртуть (Mercury, blood; Hg) | 1,200 |
| Свинец (Lead, blood; Pb) | 1,200 |
| Селен (Selenium, blood; Se) до 6 р.д. (зеленая пробирка без геля) | 1,200 |
| Таллий (Thallium, serum; TI) (сыворотка крови) | 1,200 |
| Цинк (Zinc, blood; Zn) | 1,200 |
| ИНВИТРО>>МОЧА биохимия | |
| 17-КС в моче (17- кетостероиды) (моча суточная; 8 р.д.) | 2,600 |
| Альбумин (моча суточная) | 590 |
| Альбумин/креатинин-соотношение в разовой порции мочи | 950 |
| Альфа-амилаза (диастаза) моча суточная | 450 |
| Анализ кала на дисбактериоз | 1,400 |
| Анализ кала на яйца гельминтов | 400 |
| Анализ мочи по Нечипоренко | 500 |
| Бета-2-микроглобулин в моче | 1,100 |
| Глюкоза (моча суточная) | 350 |
| ДПИД утренней мочи | 1,700 |
| Исследование соскоба на энтеробиоз | 550 |
| Калий, натрий (моча суточная) | 400 |
| Кальций (моча суточная) | 400 |
| Катехоламины суточной мочи (адреналин, норадреналин, дофамин) 5 р.д. | 2,900 |
| Копрограмма (до 4 р.д.) | 900 |
| Кортизол (моча суточная; до 8 р.д.) | 1,250 |
| Креатинин (моча суточная) | 400 |
| Метанефрины суточной мочи (моча с консервантом; до 5 р.д.) | 3,900 |
| Мочевая кислота (моча суточная) | 400 |
| Мочевина (моча суточная) | 400 |
| Общий анализ мочи | 600 |
| Общий белок (моча суточная) | 400 |
| Панкреатическая эластаза 1 (иссл. материал - кал; до 5 р.д.) | 3,400 |
| Посев мочи на микрофлору и определение чувствительности к АМП | 1,500 |
| Посев мочи с определен. чувствительности к АМП (ускоренный) 1 день | 1,900 |
| Посев мочи с опрелелением чувств. к АМП и бактериофагам (ускорен) 1 день | 2,100 |
| Посев флору и определение чувств-ти к расш. спектру АМП | 2,000 |
| Проба Реберга (моча суточная) | 480 |
| Фекальный кальпротектин (иссл. материал - кал; до 8 р.д.) | 4,100 |
| Фосфор (моча суточная) | 450 |
| Хеликобактер пилори (антигенный тест; кал) | 1,300 |
| ИНВИТРО>>ОНКОМАРКЕРЫ | |
| HE4 (Human epididymis protein 4) | 1,700 |
| NSE (нейро-специфическая енолаза) | 2,200 |
| UBC (антиген рака мочевого пузыря) | 3,000 |
| b-ХГЧ | 700 |
| b-ХГЧ свободный | 1,050 |
| АФП | 750 |
| ПСА общий | 960 |
| ПСА общий/свободный | 1,100 |
| Плацентарный фактор роста PIGF | 4,700 |
| Профиль "Оценка риска рака яичников до менопаузы" ROMA1 (НЕ4+СА-125) | 2,400 |
| Профиль "Оценка риска рака яичников после менопаузы" ROMA 2 (HE4+ CA125) | 2,400 |
| РЭА | 1,150 |
| СА 72-4 | 1,650 |
| СА-125 | 1,150 |
| СА-15-3 | 1,200 |
| СА-19-9 | 1,190 |
| Такролимус (до 8 р.д.) | 3,000 |
| ИНВИТРО>>ПРОФИЛИ ИССЕДОВАНИЙ | |
| Адреногенитальный синдром, ген CYP21А2, ч.м. (до 23 р.д.) | 64,000 |
| Витамины группы В (В1,В2,В3,В5,В6,В7,В9,В12) | 71,400 |
| Гестозы и фетоплацентарная недостаточность без описания генетиком | 11,950 |
| Гистологическое исследование материала | 4,000 |
| Лактазная недостаточн. у взрослых (ген LCT) (неперен-сть лактозы) без опис. | 1,650 |
| Молекулярно-генетическое исследование HLA-B27 (до 7 р. д.) | 2,800 |
| Мужское здоровье 18+ оптимальное обследование | 10,500 |
| Мужское здоровье 18+ расширеное обследование | 23,000 |
| Насл. случаи рака мол. железы и/или яичников, 4 гена с закл. генетика (18 р.д.) | 12,100 |
| Наслед. случаи рака мол.жел. и/или яичников, 2 гена с закл. вр.-ген.(до 14 р.д.) | 6,500 |
| Остеопороз: полная панель | 5,000 |
| Привычное невынаш. берем-ти (в т.ч.скл. к тромбозам)+закл. вр.-ген. (до 15 р.д.) | 10,450 |
| Профиль боли в суставах 63 (ОБС) + ДПИД утренней мочи (банка ) | 12,000 |
| Профиль исследован. кардиориск (10 показателей) | 8,300 |
| Профиль исследований № 15: биохимия крови (13 показателей) (не делают) | 2,420 |
| Расшир .исслед.генов сист. гемост.F2 MNYFR/MTR/MTRR/F13A1/FG/// с опис. до 17р.д | 13,200 |
| Сердечно-сосудистые заболевания с закл. врача-генетика (до 18 р.д.) (не делают) | 22,550 |
| Склонность к тромб. при беременности (гены F2, F5)+закл. генетика (11 р.д.) | 3,300 |
| Скрытый дефецит железа | 1,950 |
| Типирование по трём генам HLA II класса HLA II (DRB1, DQA1, DQB1) до 9 р. д. | 10,100 |
| Тромбозы: сокращённая панель (гены F2, F5)+закл. генетика (11 р.д.) Лейден.мутац | 3,300 |
| Тромботические осложнения при стимуляции овуляции с закл. генетика (до 15 р.д.) | 3,000 |
| Хочу стать мамой (осложнен.берем.гены F2 F5MTHFR.MTRR.MTRACF AGT RHD) не делают | 19,800 |
Цены указаны в рублях, не облагаются НДС
для корпоративных клиентов